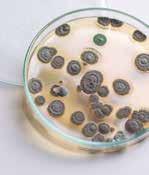

MATE MÁTICAS 2 . o ESO Rumbo a

¿Qué encontrarás en este cuaderno?
Refresca tus conocimientos de cálculo, álgebra, geometría, medida, estadística y probabilidad de una manera práctica y amena para empezar el próximo curso con buen pie. ¡PISTA!
Los contenidos se agrupan en seis semana s de cinco días . Para facilitarte la gestión del tiempo , cada semana se especifican las páginas que puedes hacer diariamente.
LOS ENGRANAJES MENTALES
Cada semana empieza con un enigma . ¿Lo sabrás resolver?










Y, para saber cómo vas de matemáticas, resuelve las actividades de las páginas siguientes.

Y, además, practica un poco más con las secciones El Reto , ¡Crea tu propio problema! y Sin calculadora .
6. Expresa en números romanos tu fecha de nacimiento:
7. Escribe en números romanos el año correspondiente a los inventos o siguientes descubrimientos:
8. Escribe

¿Cuántas tomateras ha plantado? c) Tenemos 150 botones distribuidos en 5 cajas iguales que contienen 3 bolsas de botones cada una. ¿Cuántos botones hay en cada bolsa? SIN CALCULADORA
Y, si algún contenido te cuesta un poco, no te preocupes: ¡te damos pistas !
EL TANGRAM Es un juego de origen chino, muy antiguo, que consiste en construir figuras utilizando las siete piezas, sin sobreponerlas.
¡Experimenta cada semana el desafío de nuevas situaciones de aprendizaje !



EN EL KAYAK, DE DOS EN DOS
No
En una hoja construimos un cuadrado y seguimos estos pasos:
una hoja construimos un cuadrado y seguimos estos pasos:
1.0 Dividimos el cuadrado por una diagonal y obtenemos dos triángulos de la misma medida.

No quiero subir con quien se pone el dedo en el ojo ni con quien lleva gafas. No quiero subir con quien lleva
1.0 Dividimos el cuadrado por una diagonal y obtenemos dos triángulos de la misma medida.

2. Dividimos uno de los dos triángulos por la mitad y obtenemos dos triángulos iguales (1 y 2).
4.0 Dividimos el trapecio anterior por la mitad y obtenemos dos trapecios idénticos.
4.0 Dividimos el trapecio anterior por la mitad y obtenemos dos trapecios idénticos.
3.0 En el otro triángulo, marcamos el punto medio del lado largo y hacemos corresponder el vértice del ángulo recto. Obtenemos un trapecio y un triángulo (3).
3.0 En el otro triángulo, marcamos el punto medio del lado largo y hacemos corresponder el vér tice del ángulo recto. Obtenemos un trapecio y un triángulo (3).
2. Dividimos uno de los dos triángulos por la mitad y obtenemos dos triángulos iguales (1 y 2).
5. En uno de los trapecios, unimos el vértice del ángulo agudo con el vértice del ángulo recto adyacente. Obtenemos un triángulo (4) y un cuadrado 5).
6. En el otro trapecio, unimos el vértice el ángulo obtuso con el vértice del ángulo recto opuesto. Obtenemos un triángulo (7) y un paralelogramo (6). 7 5 1 2 6 3 4
5. En uno de los trapecios, unimos el vértice del ángulo agudo con el vértice del ángulo recto adyacente. Obtenemos un triángulo (4) y un cuadrado 5).
6. En el otro trapecio, unimos el vértice el ángulo obtuso con el vértice del ángulo recto opuesto. Obtenemos un triángulo (7) y un paralelogramo (6). 7 5 1 2 6 3 4
¿Con quién quiere subir cada personaje al kayak? 2 ¿Puedes construir esta barca utilizando todas las piezas del tangram?
Y, cuando te apetezca, puedes leer las curiosidades o hacer los pasatiempos que encontrarás en el Cajón de sastre (en las últimas dos páginas de cada semana).
EL TANGRAM EN LÍNEA
EL TANGRAM EN LÍNEA
Si te gusta, puedes buscar otras imágenes por internet e intentar encontrar la solución o bien jugar con las piezas y poner nombre en la figura encontrada.
Si te gusta, puedes buscar otras imágenes por internet e intentar encontrar la solución o bien jugar con las piezas y poner nombre en la figura encontrada. EN EL KAYAK, DE DOS EN DOS
El solucionario está al final del cuaderno. Utilízalo correctamente y procura no mirarlo hasta que no hayas hecho las actividades.
2 4 5
LOS 4 CUATROS

¡Recuerda la jerarquía de las operaciones!
¡Usa los paréntesis!
¡En algún caso hay más de una solución!
¿LO RESUELVES?
Con 4 cuatros, la suma, la resta, la multiplicación y la división, ¿sabrías encontrar los números del 1 al 9?
∞ 0 = 4 + 4 – 4 – 4 = 44 – 44 = (4 – 4) · 4 · 4
∞ 1 =
∞ 2 =
∞ 3 =
∞ 4 =
∞ 5 =
∞ 6 = 4! : 4 + 4 – 4
∞ 7 =
∞ 8 =
∞ 9 =
¿Te atreves a llegar hasta el 20?

NÚMEROS
NATURALES Y DIVISIBILIDAD
1. Aplica las propiedades de las operaciones y completa los espacios vacíos:
a) 2 + = 3 + 2 = 5
b) (2 + 3) + = + (3 + 5)
c) 3 + = 3
d) · 5 = · 3 = 15
e) (2 · 4) · = · (4 · ) = · 3 = 2 · 12 =
f) 5 · = 5
Conmutativa de la suma
Asociativa de la suma
Existencia de elemento neutro de la suma
Conmutativa del producto
Asociativa del producto
Existencia de elemento neutro del producto
g) 9 · ( + 3) = · 2 + · 3 = 18 + = Distributiva de la suma con respecto al producto
¡PISTA!


2. Completa los espacios vacíos y escribe qué propiedad aplicas:
a) 5 + 2 = 2 + =

Propiedad
b) 2 + ( + 4 ) = ( 2 + 3) + Propiedad
c) 3 · ( + 4 ) = ( 3 · 4 ) + ( · 5 ) = 12 + = Propiedad
d) 4 + = 5 + Propiedad
3. Aplica la propiedad distributiva y resuelve:
a) 2 · (6 + 5) = + =
b) 3 · (1 + 4) = + =
c) 3 · (3 + 4) = + =
d) 4 · (1 + 2) = + = e) 1 · (2 + 5) = + = f) 5 · (3 + 4) = + = g) 2 · (1 + 1) = + = h) 3 · (5 + 2) = + =
4. Haz estas operaciones con números naturales:
a) 16 – 4 · 3 =
b) 83 + 12 · 4 – 9 = c) (15 – 9) · 8 : 6 = d) (3 + 4) · 25 – (32 + 28) =
5. Añade los paréntesis que haga falta para que estas operaciones sean correctas:
a) 5 + 2 · 3 = 21 b) 5 · 4 – 2 · 3 = 30 c) 15 – 6 · 8 = 72 d) 8 + 10 :
=
6. En la piscina de niños caben 7 grupos de 4 tumbonas y en la piscina de mayores, 8 grupos de 4 tumbonas. ¿Cuántas tumbonas hay entre las dos piscinas?


7. Elige la expresión numérica que corresponde a cada enunciado: (33 – 12) · 2
a) Para julio se inscribieron en las colonias de verano 33 alumnos de un instituto y para agosto, 12 más. En agosto, sin embargo, hubo 2 que anularon la inscripción. ¿Cuántos alumnos fueron de colonias finalmente?
b) 33 chicos se han inscrito en un curso de verano de inglés. En mayo se habían inscrito 12 chicas, pero en el mes de junio ya se había doblado esta cifra. ¿Cuántos chicos y chicas se han inscrito en el curso de inglés en total?
c) En unas colonias se han apuntado 33 chicos y 33 chicas de entre 12 y 13 años. Chicos, hay 12 que tienen 12 años y, de chicas, el doble. ¿Cuántas chicas tienen 13 años?
d) En un curso de verano de francés básico se han apuntado 33 chicos y chicas en total, y en el nivel intermedio, 33 más. En los dos cursos está la misma proporción de chicos que de chicas. Si en el nivel básico hay 12 chicos, ¿cuántas chicas hay entre los dos grupos de francés?
8. Un campesino ha vendido 75 kg de tomates, a 2 €/kg, y 38 kg de pimientos, a 3 €/kg. ¿Cuánto ha obtenido por la venta de la mercancía? Elige la respuesta correcta: (75 + 38) · 2 + 3 (75 + 38) · (2 + 3) 75 · 2 + 38 · 3
9. Disponemos de dos campos de cultivo con 15 y 20 manzanos, respectivamente. Esperamos obtener 35 kg de manzanas por árbol. Envasaré la producción en cajas de 10 kg cada una y las venderemos por 4 €. ¿Cuánto dinero esperamos ingresar por la producción de los dos campos? Elige la respuesta correcta:
15 + 20 · (35 : 10 · 4) (15 + 20) · 35 : 10 · 4
15 + 20 · 35 : 10 · 4

1. En un laboratorio farmacéutico se almacenan las cajas de medicinas en 100 cajones. Dentro de cada cajón hay 20 separadores y en cada separador hay 20 cajetines, que contienen 20 pastillas cada uno. ¿Cuántas pastillas hay en este laboratorio?

2. Expresa en forma de una única potencia:
a) 44 · 45 : 43 =
b) (62 · 63) / 30 =
c) 86 : 82 · 84 =
d) 74 · 75 · 72 · 73 =
¡PISTA! N · 10a exponente entero potencia de 10
decimal con la parte entera del 1 al 9
e) (52 · 53 · 52 · 5) / 57 =
f) 86 : 82 · 34 =
3. Expresa estos números en notación científica:
∞ 1 000 000 = 1 · 106 ∞ 220 000 = 2,2 · 105
a) 90 000 000 =
b) 257 =
4. ¿Sabes cuál es la distancia entre la Tierra y el Sol? Averígualo y exprésala en kilómetros. Después, escríbela en notación científica.
c) 453 000 000 =
d) 2 235,4 =

5. Investiga la superficie que ocupa la Antártida y exprésala en kilómetros cuadrados. Después, escríbela en notación científica.
∞ ¿Cuál es la superficie de España? Exprésala en kilómetros cuadrados y en notación científica.
∞ Ahora, compara las áreas de la Antártida y España. ¿Cuántas Españas caben en la Antártida? ¡PISTA! ba base exponente
SISTEMA DE NUMERACIÓN ROMANO
I = 1 V = 5 X = 10 L = 50 C = 100 D = 500 M = 1 000
• No se pueden escribir más de tres letras iguales seguidas.
• Cuando las letras I, X y C están situadas a la izquierda de otra letra de más valor, el valor de aquellas se resta del valor de esta.
6. Expresa en números romanos tu fecha de nacimiento:
7. Escribe en números romanos el año correspondiente a los inventos o siguientes descubrimientos:

James Watt máquina de vapor

Alessandro Volta pila (batería eléctrica)

SIN CALCULADORA

Antonio Meucci teléfono
Fleming penicilina
8. Escribe los siguientes números en el sistema de numeración romano:
a) 254
b) 3 250
c) 459
d) 89
Resuelve mentalmente estas cuestiones y anota el tiempo que has dedicado. Si tienes un cronómetro, lo puedes poner en marcha antes de empezar.
a) Marina ha llegado a casa 3 horas después de Juan. Y este ha llegado 2 horas después de las 9. ¿A qué hora ha llegado Marina?
b) Un campesino ha plantado tomateras en 3 terrenos. En cada terreno ha plantado 10 filas, con 8 tomateras en cada una. ¿Cuántas tomateras ha plantado?
c) Tenemos 150 botones distribuidos en 5 cajas iguales que contienen 3 bolsas de botones cada una. ¿Cuántos botones hay en cada bolsa?
9. Descompón estos números en factores primeros y calcula el mínimo común múltiple y el máximo común divisor:
∞ 60 y 42
60 = 22 · 3 · 5
42 = 2 · 3 · 7
mín. c. m (60, 42) = 22 · 3 · 5 · 7 = 420 máx. c. d. (60, 42) = 2 · 3 = 6
a) 30 y 25
b) 36 y 81
10. Aplica los criterios de divisibilidad e indica si los números siguientes son divisibles por 2, 3, 5 y 10:
a) 1 324 b) 3 300 c) 945
11. Un ayuntamiento está rehabilitando un paseo y quiere poner papeleras cada 90 m y farolas con ledes cada 70 m. Si al inicio del paseo pone una papelera y una farola, ¿al cabo de cuántos metros volverán a coincidir una papelera y una farola?

12. El comedor de una pizzería mide 5 m de largo y 6 m de ancho. Las baldosas del suelo son cuadradas. Si no han cortado ninguna baldosa, ¿crees que las baldosas pueden medir 20 cm de lado? ¿Y 30 cm? ¿Cuánto medirán las baldosas mayores que podrán poner sin tener que cortarlas?
¿Cuántos centímetros de cinta se necesitan para empaquetar una caja de 15 cm × 15 cm × 30 cm como la de la figura?
NÚMEROS ENTEROS
1. Expresa las siguientes situaciones con un número entero:
a) La temperatura en San Petersburgo el 5 de enero llegó a 25 °C bajo cero. °C
b) Carla debe a Víctor 250 €. Está en números rojos. €
Números enteros
Números negativos
Números naturales (positivos)
c) Euclides, el padre de la geometría, nació 325 años antes que Jesucristo. a. C.
d) Bill Gates, el creador del sistema operativo Windows, nació 1 955 años después que Jesucristo. d. C.
2. En un videojuego de estrategia los jugadores ganan y pierden una moneda denominada indio. Si Carla la semana pasada ganó 35 indios y esta ha perdido 40, ¿cuántos indios tiene?
3. La deuda de un pueblo de 1 200 habitantes es tan elevada que se calcula que cada ciudadano debe 400 €. ¿Cuál es la deuda total? Expresa el resultado con un número entero.
4. Resuelve las siguientes cuestiones:
a) Escribe un número entero que sea mayor que –2 y menor que 3.
b) Ordena de menor a mayor los números –12, 4, 6, –6, 14 y –17.
c) Representa en esta recta real los números del apartado anterior.
5. El año pasado la temperatura más baja en la Antártida fue de –89 °C, mientras que en el Ártico la mínima absoluta registrada fue de –67 °C. ¿En cuál de las dos zonas se llegó a una temperatura más baja?
6. Laia hace volar una estrella cerca de la playa. La estrella está a 50 m por encima de la superficie del mar. De sopetón, Laia se mete en el agua y decide sumergirse 15 m con la estrella bien cogida. ¿A qué altura sobre el nivel del mar se encontrará ahora la estrella si la longitud del cordel no varía?

7. Resuelve estas situaciones:
∞ Tengo 5 € y me dan 3. Por lo tanto, +5 + (+3) = +8; tengo 8 € Debo 5 € a Pablo y 3 € a Juan. Por lo tanto, –5 + (–3) = –8; debo 8 €
a) Tengo 5 € y debo 3: +5 + (–3) = +2. Cuando pague la deuda, tendré € .
b) Tengo 3 € y debo 5: +3 + (–5) = –2. Cuando haya pagado una parte de la deuda, todavía deberé €
8. Paula veranea en la Costa Brava y ha ahorrado durante todo el año para poder pagarse sus gastos en verano. Para controlar sus ingresos y sus gastos, quiere rellenar la siguiente tabla. Ayúdala a completarla.
Concepto
Valor (€) Dinero disponible
Ahorro acumulado durante el año +580 +580
Patines en línea –125 +455
Cuaderno de verano para repasar –12
Decoración y comida para la fiesta de aniversario
Regalo de la tía María
–283
+100
Excursión con los amigos –50
Regalo de los padres

+125
9. Dos avionetas sobrevuelan una playa donde se practican diferentes tipos de deportes acuáticos: navegación en kayak, esquí y buceo.
a) Una avioneta se encuentra a 750 m sobre el nivel del mar y la otra, a 450 m. ¿Qué diferencia de altitud hay entre la avioneta que vuela más alto y el kayak?
b) Dos buzos se encuentran a 16 m y a 25 m, respectivamente, bajo el nivel del mar. Indica con números enteros la altitud de cada uno.
c) ¿Cuál es la diferencia entre la altitud de la avioneta que vuela más bajo y la del buzo que se encuentra más cerca de la superficie?

2 4 5 3DÍA
10. Resuelve estas operaciones combinadas con números enteros:
a) 9 : (–7 + 10) −2 · (–5) =
b) –14 : (–2) + (–2) · (5 − 7) =
c) 9 : (–3) – 3 · [–8 − (–10)] =
d) [–91− (–1)] : [8 + (–10)] · (–2) =
11. Un submarino que se encuentra en la superficie del océano Índico se sumerge a una velocidad de 8 m por minuto. Expresa con un número entero la altitud del submarino 5 minutos después de iniciar la inmersión. Expresa, también, la altitud del submarino media hora después de iniciar la inmersión.

12. Escribe y resuelve la operación combinada que expresa esta situación:

SIN CALCULADORA
Irene compra cada día de la semana (de lunes a viernes) 4 sándwiches diarios, que cuestan 1,30 € cada uno, y 10 bocadillos para los monitores del gimnasio, que cuestan 3 € cada uno. Irene se pregunta cuánto dinero gasta cada semana en estas compras.
Resuelve las siguientes cuestiones
a) Un submarinista se encuentra a 14 m bajo el nivel del mar y quiere bajar hasta 53 m. Explica qué operación con números enteros hay que hacer para determinar cuántos metros más tiene que sumergirse y escribe el resultado.
b) Un avión que se encuentra a 9 500 m del suelo quiere estabilizarse a 3 650 m. Explica qué operación hay que hacer para determinar los metros que tendrá que bajar el avión y escribe el resultado.
1. Un conocido youtuber ha colgado esta semana 6 vídeos cada día, los cuales han recibido, por término medio, 3 000 «likes» y 1 200 «dislikes». La plataforma le paga 5 céntimos por cada «like» y le descuenta 2 por cada «dislike».
a) ¿Cuánto cobrará por los vídeos de esta semana en concepto de «likes-dislikes»? Haz los cálculos en céntimos y, después, pásalos a euros.
b) Además, cobra 20 céntimos por cada 10 000 visualizaciones de sus vídeos. Si esta semana han visualizado sus vídeos 10 millones de personas, ¿cuánto cobrará por estas visualizaciones?
2. En el mar Mediterráneo hay un barco hundido situado a 242 m de profundidad. Un avión que vuela a 8 145 m sobre el nivel del mar pasa por encima del lugar donde está el barco. ¿Qué distancia hay entre el avión y el barco?
Completa la siguiente pirámide teniendo en cuenta que hay que operar con los números contiguos. Empieza por las filas inferiores y ve escribiendo los resultados en las filas superiores sucesivas.

2 4 5 3
ORGANIZAMOS UNAS VACACIONES
Este verano, Víctor y Marco harán un viaje de 8 días a Polonia. Para hacer una estimación del dinero que se gastarán, cada uno ha elaborado un presupuesto:
Concepto
Billetes de avión
Víctor Marco
550 €/persona
Gastos totales en gasolina y en peajes 380 €
Gastos en actividades y compras 70 € diarios/persona 80 € diarios/persona
Hotel *** (1 habitación para 2) 60 € diarios
Apartamento en cocina 80 € diarios
Gastos en alimentación (comida y cena) 50 € diarios 25 € diarios
Gastos en tarjetas de transporte público 25 €/persona 25 €/persona

1. ¿Cuánto suma el presupuesto por persona de cada amigo?
¿Cuál es el presupuesto más bajo? ¿Cuál es la diferencia entre los dos presupuestos?
2. A partir de los dos presupuestos, indica brevemente cuáles son las diferencias principales entre el viaje que ha planificado Víctor y el que ha planificado Marco; por ejemplo: dónde comerán, dónde dormirán, etc.
3. Polonia, a pesar de ser un país de la Unión Europea, tiene su propia moneda: el zloty. El cambio hace que, por cada euro, te den, aproximadamente, 4 zlotys. ¿Cuál es el precio en zlotys de la tarjeta de transporte público durante 8 días?
4. Finalmente, los dos amigos han decidido hacer la modalidad de viaje que ha planificado Marco. Cada uno lleva el dinero calculado según este presupuesto y 150 € más para imprevistos. ¿Cuántos zlotys tiene que llevar cada uno?
5. Han planificado la ruta en coche con el fin de encontrar un área de descanso con restaurante cada 30 km y una gasolinera cada 50 km. ¿Cada cuántos kilómetros encontrarán un área de descanso con restaurante y gasolinera?
6. En Varsovia, Marco y Víctor han comprado varios regalos:
Camiseta: 72 zlotys

Zapatos: 120 zlotys
Libro de fotografías: 60 zlotys
• ¿Cuántos euros se han gastado en regalos entre los dos?
Embutido tradicional: 48 zlotys
7. Durante la visita a Varsovia han visitado el centro Copernicus, dedicado a la difusión de la cultura científica. En la entrada hay un mensaje muy curioso; para leerlo, hace falta resolver diferentes operaciones y sustituir el resultado por la letra correspondiente.
1. 43 – 5 · 4
2. 70 : (8 + 2 · 3)
3. 68 – (7 · 8)
4. 3 · (2 – 1 + 3) · (4 + 3 – 6)
5. (9 – 4 · 2) · (36 : 12)
6. 5 · 3 + (54 – 6 · 9)
7. 25 : 5 + 2 · 4
8. 24 : (5 + 3 – 2) + 1

8. En la fachada de varios edificios históricos de Cracovia hay inscripciones en números romanos con el año de construcción. Ayuda a Marco y Víctor a interpretar estas inscripciones:
a) Castillo de Wawel: MXXXVIII
b) Catedral de Wawel: MCLIV
c) Iglesia de Santa Ana: MCCCLXXIX
d) Sukiennice (mercado de artesanos renacentista): MDLV
EL ROBOT
En el centro de verano estamos construyendo un robot que es capaz de avanzar por un laberinto. El monitor nos ha explicado que utilizaremos un lenguaje de programación muy sencillo: solo hay que indicar en el robot las coordenadas cartesianas. Parece fácil; de hecho, es casi como jugar al juego de hundir barcos.
1. Para practicar con este lenguaje de programación, hemos construido un plano en que hemos representado dos pueblos, unas piscinas públicas y una zona de ocio con cines. También hemos representado un río que se puede atravesar por dos puentes y una serie de caminos.
Puente
Camino Ríos
a) Indica las coordenadas de los puntos naranja, azul, rojo y verde.
b) ¿Qué indicaciones hay que dar a una persona que quiera ir desde el punto azul (la piscina) hasta el verde (el cine)?



c) Completa estas indicaciones utilizando las direcciones N, S, E y O para guiar a Carla hasta los cines:
Sale de la piscina y toma la dirección . Adelanta 200 m y gira en dirección
Adelanta 500 m y toma dirección . Adelanta 200 m y gira en dirección . Adelanta 200 m más y gira en dirección . Seguidamente, avanza 1 200 m, atraviesa el puente y va en dirección y avanza 300 m.
2. Una manera muy útil de indicar rutas en el robot consiste en utilizar números enteros y una cuadrícula. Se trata de situarse en el punto de partida y expresar el desplazamiento mediante el código siguiente:
Indicar cuántos cuadrados hay que adelantar horizontalmente. Cuando se avanza hacia la derecha (el este), se utiliza el signo positivo, y cuando se adelanta hacia la izquierda (el oeste), el signo negativo.
Indicar cuántos cuadrados hay que adelantar en vertical. Cuando se avanza hacia arriba (el norte), se utiliza el signo positivo, y cuando se adelanta hacia abajo (el sur), el signo negativo.
a) Observa el gráfico de la derecha y completa la siguiente oración:
Para ir del punto azul (+3, +1) al punto rojo ( , ) hay que adelantar 5 cuadrados hacia la izquierda y cuadrados hacia arriba. Por lo tanto, el desplazamiento es (–5, ).
b) Indica el desplazamiento que hay que hacer para ir del punto rojo al verde.
3. Sitúa en los ejes de coordenadas anteriores el punto A (+2, –2). Después, sitúa el punto B. Para hacerlo, sigue estas instrucciones:
• Desde el punto A, desplázate 2 unidades hacia el sur y después 3 unidades hacia el este.
• Codifica el punto B en relación con los ejes de coordenadas.
4. ¿Cómo indicarías con este sistema de codificación el desplazamiento que hay que hacer, en la primera actividad, para ir del punto azul al punto verde?

EL CUADRADO MÁGICO DE LA FACHADA DE LA PASIÓN DE LA SAGRADA FAMILIA
Mientras se contempla la fachada de la Pasión y todo el conjunto escultórico de Subirachs, más de una vez, el visitante se sorprende al descubrir unos números cruzados dentro de un cuadrado y se pregunta: «¿Qué significan estos números»?.
En realidad, se trata de un cuadrado mágico, pero de una fuerza especial.
Un cuadrado mágico es la disposición de una serie de números situados dentro de una parrilla cuadrada de manera tal que la suma de los números por filas, columnas o diagonales es la misma. Esta cifra resultante es lo que se denomina constante mágica del cuadrado.
Los cuadrados mágicos posibles empiezan con el de 3 × 3, ya que el de 2 × 2 no tiene solución posible y el de 1 × 1 no tiene sentido.

Normalmente, se trata de colocar los números enteros y correlativos hasta completar la parrilla; es decir, en un cuadrado de 3 × 3 habría los números desde el 1 hasta el 9, y en un cuadrado de 4 × 4 habría los números desde el 1 hasta el 16. Con estas reglas de partida, la constante mágica no se puede escoger y depende de la suma de todos los números utilizados. Por ejemplo, en un cuadrado mágico de 3 × 3, en el que la suma «1 + 2 + 3 + 4 + 5 + 6 + 7 + 8 + 9 = 45», cada fila, columna o diagonal suma 45/3 = 15; en un cuadrado mágico de 4 × 4, en el que la suma de todos los números del 1 al 16 es 136, la constante mágica es 136/4 = 34. De esta misma manera, en un cuadrado de 5 × 5, la constante sería 65; en uno de 6 × 6, 111, y en uno de 7 × 7, 175.
1
15
¡Fíjate en este cuadrado mágico!
¿Sabrías hacer uno tú?
¡Constante mágica!
+ 7 + 6 = 15
de orden 4, te atreves?
¡EL ROMANESCO ES FRACTAL!
Hablando de cuadrados. ¿Quieres hacer un fractal?
a) Coge una hoja cuadriculada y pinta una figura como esta (hazlo 8 veces).
b) Recorta las figuras y engánchalas de esta manera. Obtienes la primera iteración.
c) ¿Quieres hacer la segunda iteración? ¡Venga! ¡Vamos!

SOLUCIONARIO
© GRUPO ANAYA, S.A., 2024 - C/ Valentín Beato, 21 - 28037 Madrid.
Reservados todos los derechos. El contenido de esta obra está protegido por la Ley, que establece penas de prisión y/o multas, además de las correspondientes indemnizaciones por daños y perjuicios, para quienes reprodujeren, plagiaren, distribuyeren o comunicaren públicamente, en todo o en parte, una obra literaria, artística o científica, o su transformación, interpretación o ejecución artística fijada en cualquier tipo de soporte o comunicada a través de cualquier medio, sin la preceptiva autorización.
